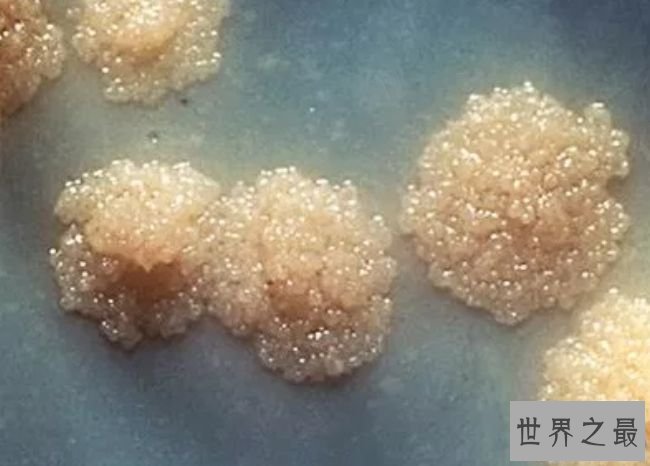
结核分枝杆菌

在这里,咱们探讨地球上最风险的10种细菌。细菌肉眼是看不到的,但四处都有,它们存在于咱们呼吸的空气中,也存在于土壤中。有些细菌对人类十分有益,但有些细菌十分风险,它们会对咱们的生命造成重大要挟。
10.肉毒杆菌
肉毒杆菌被以为是最风险的细菌之一,它的指标是人类的神经系统。它们会导致重大的瘦弱并发症,如呼吸同样、吞咽艰巨、身材虚弱和视力差。
9.大肠杆菌
这种细菌很小,但在人体内以令人难以置信的速度繁衍。它寄生在人的肠道中,一些大肠杆菌能够导致肠道出血,这种细菌的某些星状蛋白对十分年轻或年老的人以及免疫毛病的病人都是十分风险的。
8.炭疽杆菌
这种细菌也被称为炭疽热,它经过皮肤进入咱们的身材,侵害咱们的肺。这种细菌是导致感冒、咳嗽和流感的最常见缘由之一,它也会对咱们的消化系统和血液循环系统产生负面影响。
7.曲霉菌
曲霉菌是最常见和最风险的细菌霉菌之一,这是血液和肺部感染的缘由,假设没有适当的治疗,这些感染最终会导致死亡。
6.鲍氏不动杆菌
鲍氏不动杆菌目前世界上最风险的细菌之一,这种细菌经过身材的受伤部位和伤口进入人体系统。经过医学钻研人员的不懈致力,目前已经钻研出了抗生素对抗这些可怕的细菌。
5.梅毒
梅毒会惹起皮肤感染和呕吐,还会干扰血液循环系统,也会妨碍咱们身材的自动脉和动脉。治疗在第一阶段和第二阶段是能够的,然而在第三阶段就很难控制这种疾病。
4.沙门氏菌
沙门氏菌是地球上最致命的细菌之一,这种细菌经过受感染者的粪便和尿液流传。沙门氏菌的携带者次要散布在南非和美国,它谢世界其余中央也很普遍。
3.葡萄球菌
葡萄球菌十分可怕,世界上大约有4万个葡萄球菌亚种。咱们的免疫系统足够强大,可能对抗大批的这些细菌,然而一旦免疫系统遭到妨碍,这些细菌就会体现出它们致命的一面。
2.链球菌
这是可怕的肺炎背后的细菌,这种细菌也是形成细菌性脑膜炎的次要缘由。人的呼吸道中总有大批的链球菌,然而,当免疫系统遭到干扰时,这些细菌的毒性就会施展作用。

结核分枝杆菌无疑是地球上最风险的细菌,它栖身在哺乳动物的脊椎上,对免疫系统会形成无奈补偿的侵害,这种细菌已经导致很多人死亡。
